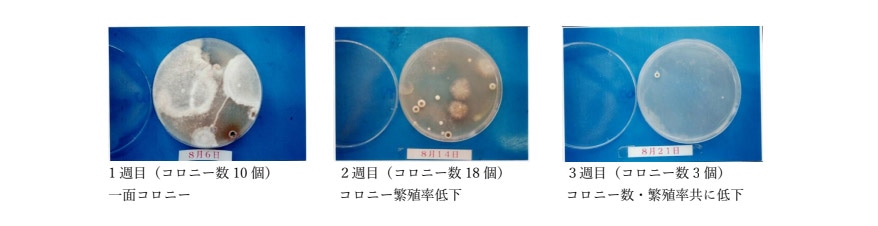

製品特長
WB-OFF は天然のわさびオイルを抽出する技術により、わさびの抗菌・消臭、防カビの効果を手軽に様々なシーンで利用できる、全く新しいバクテリアオフスプレーです。
カメラレンズの命を奪うとも言われている「カビ」が、カメラバッグ内で繁殖しないようにするにはどうすれば良いかに着目し、たどり着いた天然の防カビ成分がわさびでした。
わさびには魚の生臭さや野菜などの腐敗を遅らせる効果があり、日本人は江戸時代から食用として用いています。
このわさびのチカラを、凝縮したわさび抽出エキスを希釈したスプレーにしたのが WB-OFF。
本来の目標であった、カメラバッグの防カビにとどまらず、家具・車の中・ペット用品・靴・生ゴミなどありとあらゆる場面で、菌・カビ・臭いに効果を発揮する製品が出来上がりました。

※ペット用品などに使用する場合は本品の成分が対象動物に有害でないか予めお調べ頂いてから使用してください。
※噴霧後十分~数十分程天然わさびの香りがしますが、短時間で消えて消臭効果が現れます。

カメラレンズの命を奪うとも言われている「カビ」が、カメラバッグ内で繁殖しないようにするにはどうすれば良いかに着目し、たどり着いた天然の防カビ成分がわさびでした。
わさびには魚の生臭さや野菜などの腐敗を遅らせる効果があり、日本人は江戸時代から食用として用いています。
このわさびのチカラを、凝縮したわさび抽出エキスを希釈したスプレーにしたのが WB-OFF。
本来の目標であった、カメラバッグの防カビにとどまらず、家具・車の中・ペット用品・靴・生ゴミなどありとあらゆる場面で、菌・カビ・臭いに効果を発揮する製品が出来上がりました。
用途イメージ

主な用途
布や革などを用いた家具製品・バッグ・車の中・ペット用品・靴・などの抗菌・消臭・防カビ※ペット用品などに使用する場合は本品の成分が対象動物に有害でないか予めお調べ頂いてから使用してください。
※噴霧後十分~数十分程天然わさびの香りがしますが、短時間で消えて消臭効果が現れます。
評価実験
食品工場発酵室内の落下菌の生息調査(天然わさびオイルを庫内に設置し1週間毎の落下菌を4日培養したもの)